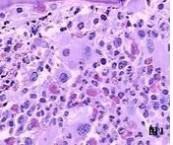

繼發性骨髓纖維化
628健康網(m.varsalchemical.com)為您匯集最新關于繼發性骨髓纖維化的健康知識大全、繼發性骨髓纖維化最新消息資訊等有關繼發性骨髓纖維化的文章知識介紹,供您參考。
繼發性骨髓纖維化
-
繼發性骨髓纖維化
628健康網為您分享有關繼發性骨髓纖維化的癥狀,繼發性骨髓纖維化的治療方法,繼發性骨髓纖維化的預防知識,繼發性骨髓纖維...
-
新生兒Rh血型不合溶血病
628健康網為您分享有關新生兒Rh血型不合溶血病的癥狀,新生兒Rh血型不合溶血病的治療方法,新生兒Rh血型不合溶血病的預防知...
-
李銘鑫
李銘鑫,男,中國人民解放軍總醫院第六醫學中心高壓氧科,主治醫師。擅長高壓氧治療相關疾病,因腦血管意外、外傷、中...
-
陳樺
陳樺,男,正畸科主治醫師。畢業于北京大學口腔醫學院,口腔正畸學博士學位。中國口腔正畸學會(COS)以及世界正畸聯盟...
-
徐州市云龍醫院
628健康網醫院大全頻道為您提供徐州市云龍醫院簡介,徐州市云龍醫院介紹,徐州市云龍醫院怎么樣,徐州市云龍醫院好不好,徐...